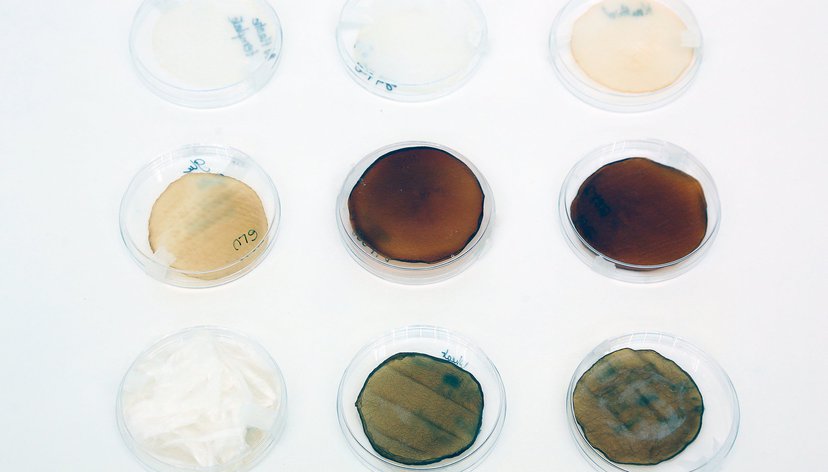
Wheat straw transformation with Acetobacter to produce bacterial cellulose, Miriam Ribul, 2019

Dr Miriam Ribul
- Senior Research Fellow in Materials Circularity for Distributed Manufacture
-
Centre for Materials Science & Culture
Miriam leads the Materials Circularity research strand of the Textiles Circularity Centre (TCC).
Her research transforms biomaterial design practices within circular and regenerative socio-ecological systems. She nurtures interdisciplinary collaborations with academic and industry partners that integrate circular design, materials science, biological sciences, advanced manufacturing and environmental sciences.
Miriam specified and developed the first Bio Lab of the Centre for Materials Science & Culture for transdisciplinary material experimentation, and she leads the intellectual strategy of the Centre’s ‘invention of materials’ themes through research funding, PhD student supervision, management of PDRAs, and public engagement.
She is Co-Investigator and leads the Materials Circularity research strand in the UKRI National Interdisciplinary Textiles Circularity Centre (TCC), and she successfully completed projects as Co-Investigator with the Biotechnology and Biological Sciences (BBSRC) Research Council, Biomass and Biorefinery Network (BBNet), and the British Academy Global Challenges Research Fund (GCRF). She was the Sustainable Future Materials theme lead of the Burberry Materials Futures Research Group, the first lab of the Materials Science Research Centre (2018-2020).
Miriam holds a PhD from the University of the Arts London (Centre for Circular Design) with the London Doctoral Design Centre, an MA in Material Futures (Central Saint Martins) and a BA in Textile Design. During her PhD, she was Visiting Researcher at RISE Research Institutes of Sweden and the School of Chemical Engineering at Aalto University, Finland.
Previously, she led a Short-Term Scientific Mission (STSM) with the European Cooperation in Science and Technology (COST) and contributed to the MISTRA Future Fashion programme funded by the Swedish Foundation for Strategic Environmental Research at the Centre for Circular Design, University of the Arts London (UAL). She consulted on sustainable and circular strategy for several international companies, and she was Visiting Lecturer and Module Lead at UAL.
Miriam’s work is published in high impact journals, and she regularly contributes to international conferences. Her practice work has made a significant impact on biomaterial design through compelling artefacts and open innovation approaches.
Key details
School, Centre or Area
Research projects
Gallery
More information
Research interests
Miriam’s research innovates the materials, mechanisms and processes that nurture actions and characteristics to transform interconnected social and ecological systems, and determines new methods for research in materials and design. Innovation in design methodology enables a whole systems perspective of materials for the correlation and integration of lifecycle stages in the context of a circular and regenerative bioeconomy.
Practice
Miriam’s process-driven and systemic practice-based approach looks to ReProgram materials, ReSet material systems, ReGenerate natural lifecycles and ReDistribute manufacturing in the bioeconomy with a focus on bio-based, biomaterials and biologically manufactured materials.
Posing the question ‘What material systems are we designing for?’ and seeking a symbiosis between natural and social systems, her approach aims to determine new applications of materials and design that explore the following themes:
- Distribution of tools and processes for accessible, viable and shared material technologies: a transition from the development of new materials to new uses of existing resources with adapted and distributed material technologies.
- Maintenance of and caring for common resources: novel restoration and maintenance processes that enable shared material systems.
- Nourishment of interdependent communities in order to empower them to build their own realities: enhancing local resources and skills in place-based contexts with the support of sustainable processes.
This practice approach encompasses the disciplines of design, materials science, biotechnology, advanced manufacturing and engineering, bioscience and ecology and embeds these into craftsmanship, communities and society - such as rethinking current systems of production or working in a place-based context.
Research funding
Co-Investigator and Lead (2021–2024), Materials Circularity strand in the Textiles Circularity Centre. UK Research and Innovation (UKRI) Interdisciplinary Circular Economy Centres Programme (NICER) (£5,436,699).
Co-Investigator (2020–2022), Bio-Manufacturing Textiles from Waste. BBSRC Super Follow-on project (£776,472).
Co-Investigator (2020–2021), Novel High-Performance Textile Composites. Biomass and Biorefinery Network (BBNet) Proof of Concept fund (£49,744).
International Collaborator (2019–2022), A Brazil-UK Network for Natural Polymers derived from Local Food Industry By-products. British Academy Global Challenges Research Fund (£23,000).
Principal Investigator (2021), Methods and methodologies for shaping Alternative Realities. Scoping project funded by the RCA RKEI Strategic Investment Fund.
Principal Investigator (2015–2018), London Doctoral Design Centre (LDoc), Arts and Humanities Research Council (AHRC) at the University of the Arts London: PhD grant.
Visiting Researcher (2018), London Doctoral Design Centre (LDoc): Aalto University’s School of Chemical Engineering.
Visiting Researcher (2017), London Doctoral Design Centre (LDoc): RISE Research Institutes of Sweden.
Visiting Researcher (2016), London Doctoral Design Centre (LDoc): RISE Research Institutes of Sweden.
Project Lead (2014), European Cooperation in Science and Technology (COST): Funding award towards leading a design-science project in ‘Design Possibilities for Regenerated Cellulose Materials’.
Researcher (2011-2015), Swedish Foundation for Strategic Environmental Research at the Centre for Circular Design, University of the Arts London (UAL): MISTRA Future Fashion.
Current and recent projects
Co-Investigator and Lead (2021–2024) Materials Circularity strand in the Textiles Circularity Centre. UK Research and Innovation (UKRI) Interdisciplinary Circular Economy Centres Programme (NICER) with University of Leeds, University of York, Cranfield University, University of Manchester, University of Cambridge and University College London.
Co-Investigator (2020–2022) Bio-Manufacturing Textiles from Waste. BBSRC Super Follow-on project with University of York and University of Leeds.
Co-Investigator (2020–2021) Novel High-Performance Textile Composites. Biomass and Biorefinery Network (BBNet) Proof of Concept fund.
International Collaborator (2019–2022) A Brazil-UK Network for Natural Polymers derived from Local Food Industry By-products. British Academy Global Challenges Research Fund.
Principal Investigator (2021) Methods and methodologies for shaping Alternative Realities. Scoping project funded by the RCA RKEI Strategic Investment Fund.
Publications, exhibitions, other outcomes
Barrios-O’Neill, D., Ribul, M., Tommencioni Pisapia, C., Yan, Y., Rungta, D., Selby, L., Ren, X., Quintana, C., Morrow, R., Lanot, A., Baurley, S., McQueen-Mason, S. (2025). 'Learning by Transforming: Widening Access to Complex Circular Economy Science using Experimental Design', Proceedings of the 6th Product Lifetimes and the Environment Conference (PLATE), Aalborg University, Aalborg, Denmark, 2 – 4 July. https://doi.org/10.54337/plate2025-10353
Morrow, R., Hassan, M.H., Daskalakis, E., Ribul, M., Lanot, A., Arshad, H., Baurley, S., Potluri, P., Jorge Da Silva Bartolo, P. (2025) ‘3D printing Bacterial Cellulose and Polyethylene Terephthalate Glycol to Reinforce Textiles for material longevity within textiles circularity’, Materials Circular Economy, 7, 6.
Zhong, S., Gatti, E., Hardwick, J., Ribul, M., Cho, Y., and Obrist, M. (2025) 'LLM-mediated domain-specific voice agents: the case of TextileBot', Behaviour & Information Technology, pp. 1–33.
Lanot, A., Tiwari, S., Purnell, P., Omar, A. M., Ribul, M., Upton, D. J., Eastmond, H., Badruddin, I. J., Walker, H. F., Gatenby, A., Baurley, S., Bartolo, P. J.D.S., Rahatekar, S. S., Bruce, N. C., McQueen-Mason, S. J. (2024) 'Demonstrating a biobased concept for the production of sustainable bacterial cellulose from mixed textile, agricultural and municipal wastes', Journal of Cleaner Production, 144418.
Tommencioni Pisapia, C., Highley, B., Ribul, M., Baurley, S. and Bruce, N. C. (2024) 'Webbing Clothes Moths from pest to opportunity: a reflective case study in interdisciplinary design-biology collaborations.' DRS2024: Boston. pp. 1-16.
Ribul, M. (2023) 'Altered Properties: Introducing a Novel Circular Cellulose–Based Binder for Printing Textile Finishes.' Materials Circular Economy, 5, 20.
Morrow, R., Ribul, M., Eastmond, H., Lanot, A., Baurley, S. (2023) 'Bio-Producing Bacterial Cellulose Filaments through Co-Designing with Biological Characteristics.' Materials, 16, 4893.
Ribul, M. (2023) ‘Circular colour: Reusing colour from previous textile lifecycles in textile finishes’, Proceedings of the 5th Product Lifetimes and the Environment (PLATE) Conference, Aalto University, Espoo, Finland, 31 May – 2 June, pp. 849-854.
Ribul, M. (2021) ‘Regenerative Textiles: A Framework for Future Materials Circularity in the Textile Value Chain’, Sustainability, 13 (24), 13910.
Ribul, M., Lanot, A., Tommencioni Pisapia, C., Purnell, P.; McQueen-Mason, S. J., Baurley, S. (2021) ‘Mechanical, chemical, biological: Moving towards closed-loop bio-based recycling in a circular economy of sustainable textiles,’ Journal of Cleaner Production 326, 129325.
Ribul, M., Goldsworthy, K. and Collet, C. (2021) ‘Material-Driven Textile Design (MDTD): A Methodology for Designing Circular Material-Driven Fabrication and Finishing Processes in the Materials Science Laboratory,’ Sustainability 13 (3), 1268.
Costa, S. A., Ribul, M., Baurley, S., Costa, S. (2020) ‘Agro-industrial waste: Raw material for textiles,’ proceedings for Sustexmoda EACH-USP, Congresso Internacional de Sustentabilidade em Textile e Moda, Sao Paulo, Brazil, 4-9 Nov.
Ribul, M. (2019) ‘Material Driven Textile Design: Designing Fully Integrated Fabrication and Finishing Processes with Regenerated Cellulose in the Materials Science Laboratory.’ PhD Thesis, University of the Arts London.
Ribul, M. and de la Motte, H. (2018) ‘Material Translation: Validation and Visualization as Transdisciplinary Methods for Textile Design and Materials Science in the Circular Bioeconomy,’ Journal of Textile Design Research and Practice (RFTD), 6(1), pp. 66-88.
Englund, F., Wedin, H., Ribul, M., de la Motte, H. and Östlund, Å (2018) Textile tagging to enable automated sorting and beyond. MISTRA Future Fashion report. Stockholm: RISE Research Institutes of Sweden.
Ribul, M. and de la Motte, H. (2016) ‘The Material Affinity of Design and Science for a Circular Economy’, Proceedings of the Circular Transitions Conference, London, United Kingdom, 23-24 November, pp. 236-248.
Earley, R., Vuletich, C., Goldsworthy, K., Politowicz, K., and Ribul, M. (2015) The Textile Toolbox: New Design Thinking, Materials and Processes for Sustainable Fashion Textiles. MISTRA Future Fashion End of Award Report (2011-2015), Sweden.
Ribul, M., Cosaca Lemos, J. and Whitehead, L. (2015) UAL Futures Learn Report: Co-designing a Digital Creative Toolkit for UAL.
Ribul, M. and de la Motte, H. (2014) Design Possibilities in Regenerated Cellulose Materials. COST, European Cooperation in Science and Technology FP 1205 project report. Borås: RISE Research Institutes of Sweden.
Ribul, M. (2013) Recipes for Material Activism.
External collaborations
EPSRC Peer Review College member.
Guest Editor, Materials (MDPI).
Board Member of the RCA Pure board.
Peer reviewer for Nature Reviews Clean Technology, Journal of Materials Science, Designs, and Journal of Textiles Research and Practice.
Member of the Biomass and Biorefinery Network (BBNet) funded by the Biotechnology and Biological Sciences Research Council (BBSRC).